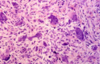
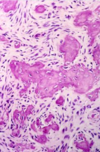

bone histology
Hard tissue but is vital
Compact bone made of osteons with haversian canal in the middle
* haversian canal has blood vessels – bone laid down in concentric lamellae bone rings (by osteoblasts)
Osteocytes sit in lacunae within the concentric lamellae
Interstitial lamellae between concentric lamellae
Circumferential lamellae – around outside
Lateral Volkman’s canals
* Allow osteocytes to communicate with each other and exchange info about environment.
Periosteum – where you find pain receptors and more vessels
Cellular, time goes get more lumbar
Osteoblasts – oval in shape, sit next each other
* Become surrounded by bone – osteocytes
* Multinucleated osteoclasts – sits on surface of bone, breaks down bone to release minerals into body if needed

bone remodelling cycles
factors
3 groups
mechanical stimuli
systemic hormones
* Parathyroid hormone (PTH)
* Vitamin D3 (hormone)
* Oestrogen
* others
cytokines – release them leads to osteoclast activation
complex interactions promote growth of cells and bone matrix
amount of bone recycled same as bone formed, net amount of bone in *skeleton is the same.
special test for bone
bone biochemistry
not easy to biopsy
bone biochemistry looks at
4
blood calcium (2.20 to 2.60 mmol/L)
osteoblast activity (bone formation)
* serum alkaline phosphatase (30 to 130 U/L)
* Osteocalcin (Vit K dependent) (< 15 ng/L)
osteoclast activity (bone resorption)
* collagen degradation urine & blood (collagen is found in bone)
parathyroid hormone (1.6 to 7.5 pmol/L)
vitamin D assays (>50 nmol/L adequate)
5 bone developmental abnormalities
torus
osteogenesis imperfecta
achondroplasia
osteopetrosis
fibrous dysplasia
torus
Developmental exostosis
Problem with fitting dentures
Torus palatinus - Midline of palate – horseshoe design, window relief
Torus/Tori mandibularis - Bilateral on lingual aspect of mandible (usually premolar region)
Benign
can be surgically reduced
not always symmetrical

CBCT scan
trabecullar bone is
cortical bone is
trabecullar bone is radiolucent
cortical bone is radiopaque

osteogenesis imperfecta
**Type 1 collagen defect **
* Inheritance varied - 4 main types (type 3 – has dentigerous imperfecta)
Clinical
* Weak bones, multiple fractures - Wheelchair bond eventually
* Sometimes associated with dentinogenesis imperfecta
achondroplasia
Autosomal dominant
Poor endochondral ossification (formation of long bones)
Dwarfism
osteopetrosis
Lack of osteoclast activity
* Failure of resorption
Marrow obliteration (due to dense cortical bone deposition)
* Anaemia and delayed healing
* Hard to extract teeth
opposite of osteoporosis
fibrous dysplasia
clincal appearance and occurence
Gene defect
Slow growing, asymptomatic bony swelling
**Bone replaced by fibrous tissue **
Active under 20years
Stops growing after active growth period – usually
Clinical phenotypes Determined by timing of gene mutation
Monostotic – single bone
* More common
* Maxilla > mandible
* Facial asymmetry
Polyostotic – many bones
* Albright’s syndrome - Melanin pigment (coffee spots on body); early puberty (under 5 for girls)

fibrous dysplasia
radiographic appearance
Variable appearances radiographically
* “Ground glass”, “orange peel”, “fingerprint whorl”, “cotton wool”, amorphous
* Abnormal trabecular bone – loss of pattern
* Margins often blend into adjacent bone
Bone maintains approximate shape (initially)
Becomes more radiopaque as lesion matures

what bone pathology is happening here

Compare to other side
Upper left quadrant – alveolar crest drops down - FIBROUS DYSPLASIA
Can get secondary lesions within – solitary bone cysts (radiolucencies within)

CBCT
axial view
look from above
CBCT
coronal view
look front on
CBCT
sagittal view
look side on
fibrous dysplasia histology
“fibro-osseous”
fibrous replacement of bone
* cellular fibrous tissue background with some bone in it
* bone – metaplastic or woven, but will remodel and increase in density (metaplastic - don’t have osteoplastic cells)
not separated – no capsule – blends into surrounding adjacent bone (both histopathologically and radiolucency)
Not exclusive to fibrous dysplasia – need clinical appearance, bone biochemistry to get clinical dx

clincal dx of fibrous dysplasia
clinical appearnce
bone biochemistry (osteoblast and osteoclast activity)
histological appearance
radiographs
should stop when pt stops growing
needs all for dx
clincal dx of fibrous dysplasia
clinical appearnce
bone biochemistry (osteoblast and osteoclast activity)
histological appearance
radiographs
should stop when pt stops growing
needs all for dx
rarefying osteitis
Localised loss of bone in response to inflammation
Always occurring secondary to another form of pathology
* If at apex of tooth consider periapical periodontitis, periapical granuloma or periapical abscess
* Non-vital tooth
* Presents more radiographically rather than clinically ?

sclerosing osteitis
Localised increase in bone density in response to low-grade inflammation
Most common around apex of tooth with a necrotic pulp
* Periapical radiopacity, often poorly-defined
* May eventually lead to external root resorption if chronic
Dense trabeculation around grossly carious tooth
Indicates area of inflammation (non-vital tooth – XLA or RCT), its just dense bone – not radiopaque tumour.
Manage stimulus to resolve
*abnormal hardening *

idiopathic osteosclerosis
**Localised increase in bone density of unknown cause **
a.k.a. dense bone island
no inflammation
Most common in premolar-molar region of mandible
Always asymptomatic
No bony expansion & no effect on adjacent teeth/structures
E.g. teeth, or IDC (tumour would displace it)

what is the cause of these two bone pathologies?

RHS - 45m idiopathic osteosclerosis
LHS - 37 sclerosising ostetitis
heavily resotred – need to sensibility testing to see if tooth vital (more likely sclerosing then)

what to do is suspect sclerosis osteitis
carry out sensibility test to see if tooth involved is vital